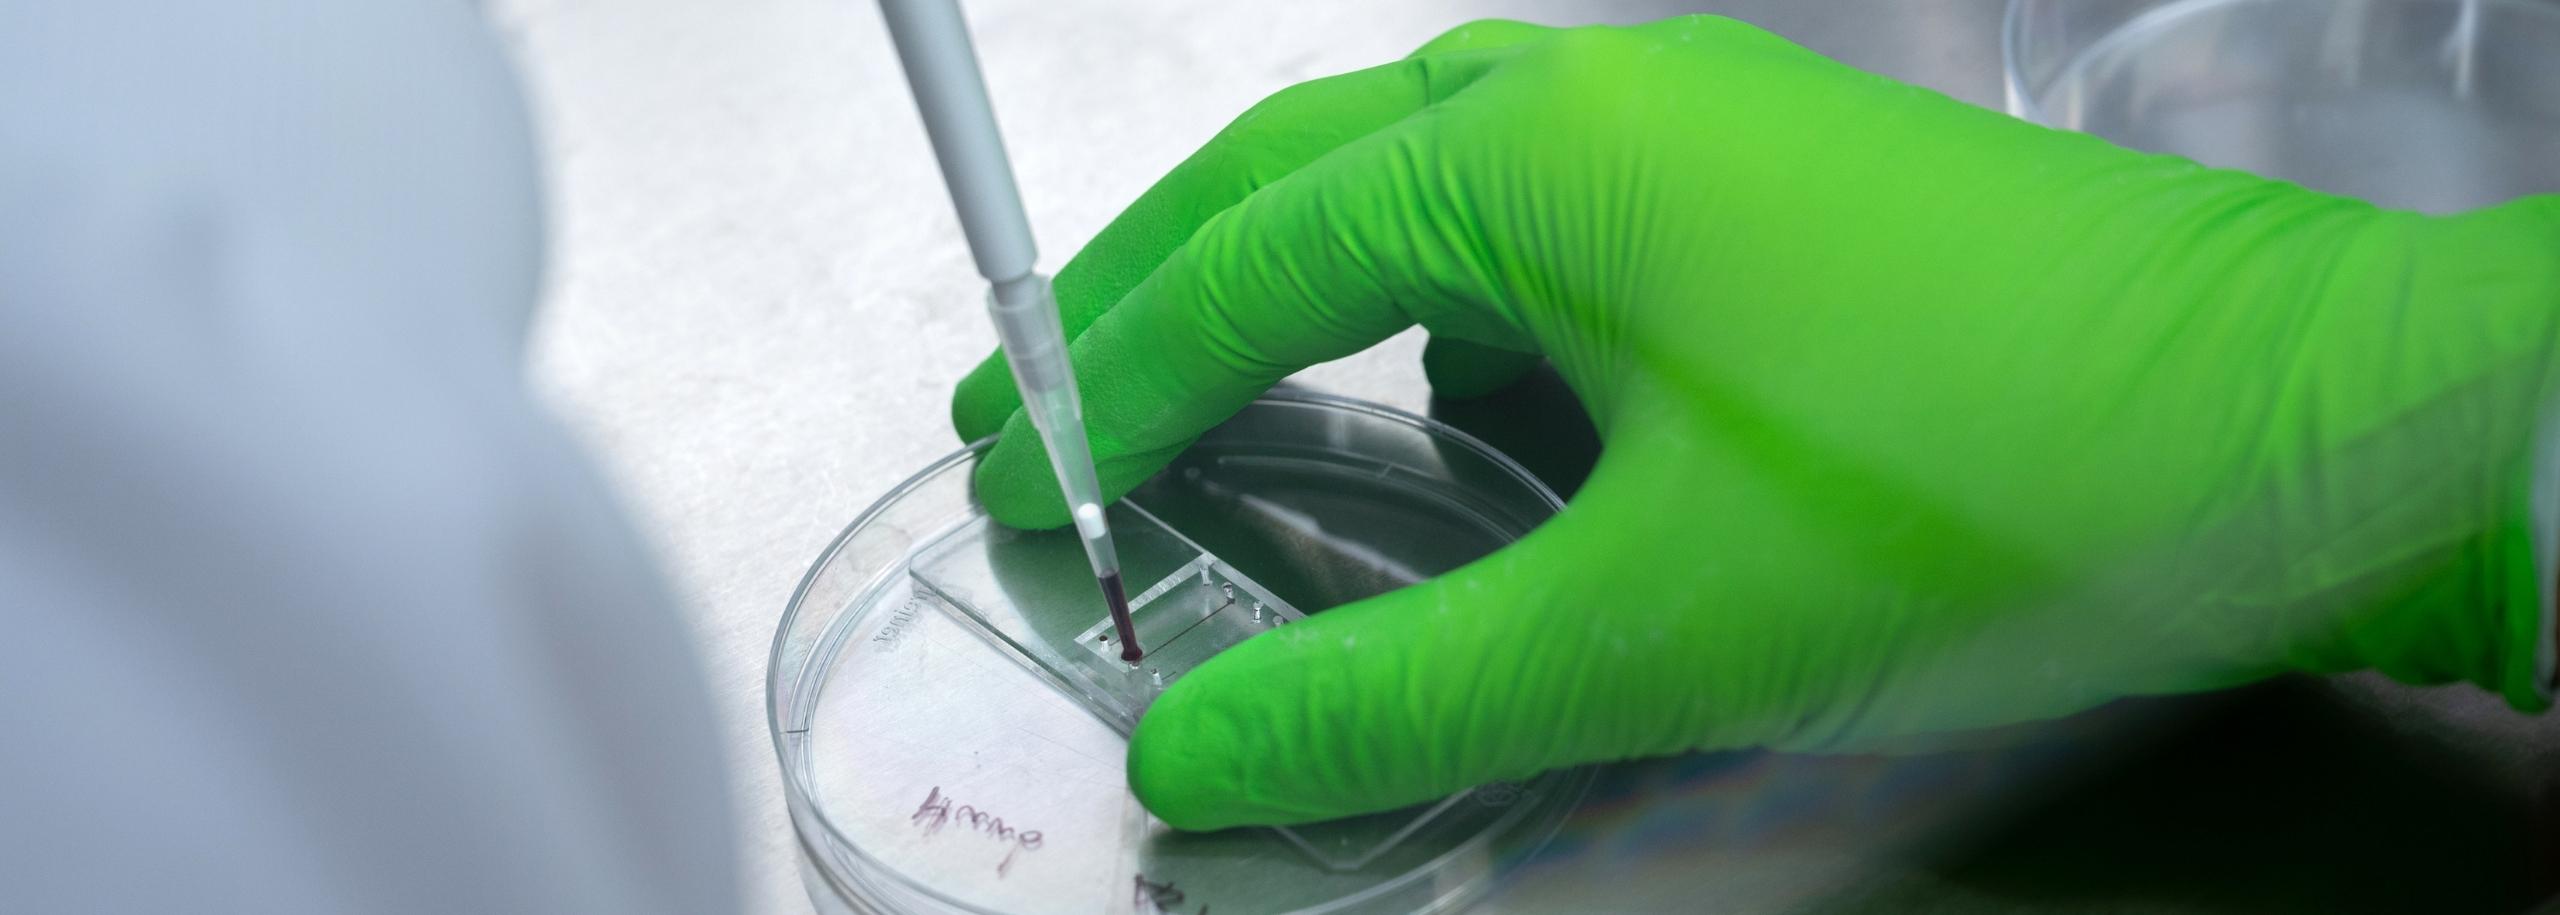

Tekst is geschreven door Huub Weener.
Welkom bij Drijfveren. Hier vertellen onderzoekers wat hen motiveert om proefdiervrije alternatieven te ontwikkelen. Dit keer is het aan onderzoeker ir. Huub Weener, werkzaam aan de Universiteit Twente.
Huub werkt, samen met de universitaire ziekenhuizen van Leiden en Amsterdam, aan een proefdiervrij corona-onderzoek. En hij werkt ook samen met dr. Andries van der Meer. Wanneer COVID-19 patiënten ernstig ziek worden, hebben ze vaak problemen in hun bloedvaten, wat kan leiden tot trombose, ook wel bloedproppen genoemd. In dit project, dat gefinancierd is vanuit Meer Kennis met Minder Dieren van ZonMw, gebruiken onderzoekers bloedvaten-op-een-chip om de ontwikkeling van bloedproppen door COVID-19 te onderzoeken.

Bloedplasma van corona-patiënten
Aan ons onderzoek doen patiënten met COVID-19 mee, die zijn binnengekomen op de spoedeisende hulp van het AMC Amsterdam. Naast COVID-19 patiënten hebben we twee controlegroepen om de COVID-19 patiënten mee te vergelijken. Een gezonde groep, die bestaat uit vrijwilligers die geen relevante klachten hebben, en een groep met patiënten met longontsteking. Deze laatste groep bestaat uit mensen die ook bij de spoedeisende hulp waren gekomen, maar die een negatieve uitslag hadden op corona. Van deze verschillende groepen nemen we bloedplasma af. Plasma is het vloeibare gedeelte van het bloed, zonder de bloedcellen en de bloedplaatjes die er normaal in zitten. Plasma bevat bijvoorbeeld ontstekingseiwitten.

Bloedprop in een bloedvat-op-chip
Wij hebben bloedvaten-op-een-chip gemaakt die lijken op de bloedvaten van de mens. We hebben in de chip namelijk een laag met cellen aangebracht die wij als mensen aan de binnenkant van onze bloedvaten kunnen vinden. We behandelen de bloedvaten-op-chip met het plasma van de verschillende donoren. Het plasma van de COVID-19 patiënten bevat veel ontstekingseiwitten, wat zorgt voor een ontstekingsreactie in de chip. Dit is in tegenstelling tot de andere twee groepen, waarbij een kleinere of zelfs geen ontsteking ontstaat.
De ontsteking die in de bloedvaten-op-chip ontstaat door het plasma van COVID-19, maken we vervolgens zichtbaar door bloed door de chip te laten stromen. Als de cellen in de chip ontstoken raken, scheiden ze stoffen uit die ervoor zorgen dat bloedplaatjes uit het bloed vast blijven zitten aan de cellaag. Dit zorgt ervoor dat er steeds meer bloedplaatjes aan vast blijven zitten, wat uiteindelijk zorgt voor een bloedprop in de chip. Dit is een proces dat op dezelfde manier ook plaats vindt in de bloedvaten bij mensen die COVID-19 krijgen.

Eerste resultaten
De eerste resultaten laten zien dat er grote bloedproppen ontstaan in de chips die behandeld zijn met het plasma van COVID-19 patiënten (zie ’thrombosis’ in onderstaande GIF-afbeelding). En dat dit niet zo is bij het plasma van gezonde mensen. Verder zien we dat er bij het plasma van COVID-19 wondjes in de cellaag te zien zijn en dat bij deze wondjes het bloed niet in de vaten blijft, maar ook daarbuiten treedt (zie ‘vessel damage’ in onderstaande GIF-afbeelding).
Belangrijke proefdiervrije modellen
Met ons onderzoek tonen we aan dat proefdiervrije modellen een belangrijke rol spelen in het begrijpen van COVID-19 en in het zoeken naar nieuwe behandelmethoden. Het gebruik van menselijk materiaal biedt unieke kansen op nieuwe wetenschappelijke inzichten en zorgt voor een directe connectie met de ziekte. Dit model kan ook voor onderzoek naar andere ziektes worden gebruikt; bijvoorbeeld voor het onderzoeken van bijwerkingen van immunotherapie voor kankerbehandelingen. Door de ontwikkeling van onze modellen en de vernieuwende inzichten die ze opleveren, wordt de noodzaak om proefdiermodellen te gebruiken voor biomedisch en farmacologisch onderzoek steeds kleiner.
Ik kreeg een paar rare blikken toen ik in onderweg naar de universiteit in de trein zat met een grote doos met het bloedplasma van coronapatiënten. Het is wel een snelle manier om de treincoupé leeg te maken, door te zeggen dat je een doos met corona naast je hebt staan!

Onderzoek geeft voldoening
We werken met biologische materialen van mensen om echt een beeld te krijgen van wat corona allemaal doet met de bloedvaten van een mens. Naast dat het gigantisch actueel is, is het ook een erg uitdagend ziektebeeld waar ik elke dag nieuwe dingen over leer. Verder is het leuk en uitdagend om direct met de arts samen te werken. Ik heb zelf een technische achtergrond, en daarmee een andere blik op ons model dan een arts. Deze samenwerking werpt vruchten af.
Leuke momenten
De samenwerking met Amsterdam en Leiden levert ook leuke momenten op. Om bijvoorbeeld een deel van het plasma van het AMC Amsterdam naar de Universiteit Twente te krijgen, was ik op een dag met een piepschuimen doos op weg in de trein. Er zat een grote bult met droogijs in de piepschuimen doos, om het plasma bevroren te houden. Ik kreeg een paar rare blikken toen ik in de trein zat met deze gevulde doos. Het is wel een snelle manier om de treincoupé leeg te maken, door te zeggen dat je een doos met corona naast je hebt staan!